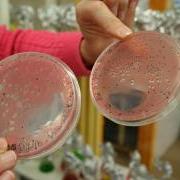
Samples of marine viruses

Evolution in Real Time: Studying Marine Viruses in Mount Hope Bay
Faculty-student collaborative research examines the evolution of marine viruses

BRISTOL, R.I. – Each month Professor of Biology Marcia Marston and her small team of student research assistants make the short trek down to the Roger Williams waterfront (a perk of researching marine life on a bayside campus) and dip a 1-liter bottle into Mount Hope Bay to collect a water sample. Even when the water appears crystal clear, it’s teeming with microscopic life – thousands of different marine microbes that make their home in the bay.
From these microbes, the research team harvests the marine viruses that infect a bacterial host known as Synechococcus (formerly called blue-green algae). How do they isolate these specific viruses from the healthy and infected microbes? It’s a scientific wait-and-see process: which microbe cultures survive and which die by virus. Once extracted, the viruses’ genes are isolated and the DNA sequences are shipped to an external lab for genetic sequencing – and that’s where Marston’s research kicks into high gear, examining the interactions between the microbial host and the marine virus. In particular, Marston is investigating how the types and diversity of viruses in Mount Hope Bay change from month to month and year to year; how the virus genome evolves in response to changing conditions (such as the host’s adaptive resistance); and whether it is always the same genes that lead to adaptation in the host and virus.
With 14 years of accumulated samples and research, Marston compares virus samples collected in the ’90s to fresh ones from the bay. Viruses grow and evolve at a rapid rate, she says – months, as opposed to years or decades, giving her a front-row seat to adaptation that Darwin would have envied.
“My research looks at evolution in real time – I’m watching evolution occur in the lab,” says Marston, whose project recently received a third round of grant funding from the National Science Foundation.
From Marston – a molecular biologist, geneticist and virologist – here are 10 facts about the constantly evolving world of marine viruses:
- Marston studies some seriously ancient life. Cyanobacteria (the marine microbe home to the virus she studies) are one of the first photosynthetic organisms on the planet, and precursors to the chloroplasts that evolved in plants.
- Marine viruses are so abundant in the ocean that you’ve definitely encountered them without knowing it – especially if you’ve ever taken a dip in the ocean. A drop of ocean water may contain 100,000 viruses. “If you’ve ever swallowed seawater, you’ve had a mouthful of what I study,” Marston says. Not to worry, though – they’re harmless to humans.
- How can ocean life survive so many marine viruses? That’s a question that Marston’s research may answer. “Coevolution is the key factor,” she says: the cell evolves resistance to a virus, which then mutates to re-infect the cell, and so on, allowing each to survive and thrive together.
- Scientists liken this effect to a nuclear arms race – as soon as a cell evolves resistance, the virus ups the ante via a mutation, which some cells will be immune to. They keep each other in check, eventually producing a sort of equilibrium, Marston says.
- At some point, though, a virus can pick up a whole new gene from another virus, which can increase its host range, Marston says. Just like strains of influenza, which frequently undergo small mutations but every so often acquire a whole new genome segment, resulting in a virulent strain such as H1N1 swine flu.
- The marine viruses she studies are pathogenic to its host cell in the short-term, Marston says, but over the long-term they acquire genes from the cell and incorporate those into its own genome. This “clever trick,” as she calls it, allows the virus to make its host’s proteins so that it can shut down the host cell’s functions while keeping it alive long enough to replicate new viruses.
- Marine viruses are constantly evolving, and Marston and her research assistants frequently find new types. Just through their research, over 300 new types have been identified in Mount Hope Bay! After recent visits to their respective homes in Long Island and New Jersey, junior Jamie Wandzilak and sophomore Alex Veglia returned with local water samples and each discovered unknown viruses; credit for discovery and genome sequencing will go to the students, who will add the new viral gene sequences to the U.S. National Institute of Health’s GenBank – an online databank containing all known DNA sequences of every organism and virus on Earth.
- The world of marine virology is nearly as small as the unicellular virus hosts. A field of study that began less than 20 years ago, Marston estimates there are about 100 marine virology research laboratories worldwide.
- In the scientific community’s ongoing debate over whether viruses are dead or alive, Marston has a definite opinion. She thinks of viruses as life – they evolve and have their own DNA, even though they depend on a host cell to replicate and survive.
- So, will a virus ever annihilate the human race? Not according to Marston. Most people may be wiped out by a super-virus, she says, “but there’s enough genetic variability in people that a virus couldn’t kill every individual. Someone would be resistant.”